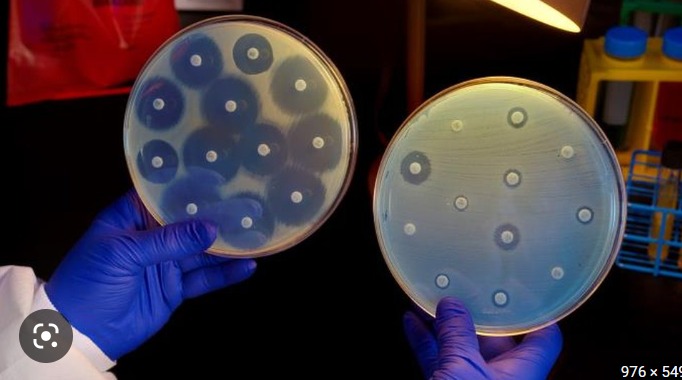

Treatment Options for Carbapenem-resistant Gram-negative Bacterial Infections. Options Against Carba-R Gram-negative and Stewardship
O manejo das infecções por bactérias Gram-negativas resistentes aos carbapenems continua sendo um grande desafio, mesmo com as novas opções terapêuticas. O artigo em anexo, além de abordar sobre os “velhas e novas” opções contra esses patógenos, faz importantes considerações a respeito do papel do stewardship desses antimicrobianos e diagnósticos rápidos, direcionando o uso racional.